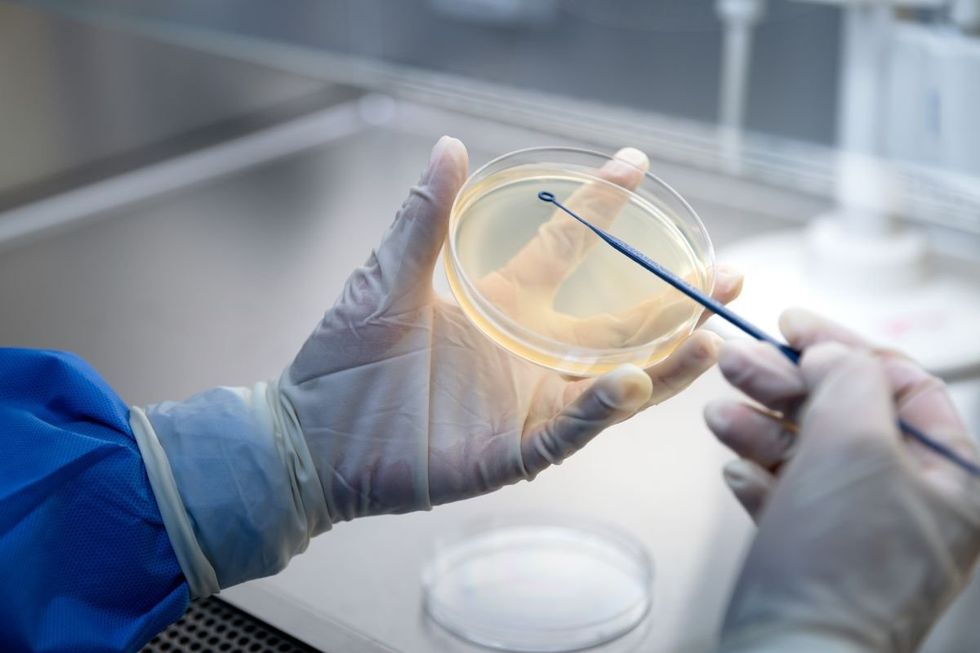
VIRUS DETECTION

Two viruses originating from animals pose risk of major outbreaks, scientists warn

Influenza D virus and canine coronavirus could spark major outbreaks without improved monitoring
Don't Miss
Most Read
Two viruses that originated in animals could pose serious risks to human health, scientists are now warning.
Influenza D virus and canine coronavirus have been quietly circulating without much attention.
Still, infectious disease experts say the conditions are right for these pathogens to spread more widely among people.
Writing in the January issue of Emerging Infectious Diseases, a CDC journal, researchers caution that without better monitoring and testing, both viruses have genuine potential to spark outbreaks.
TRENDING
Stories
Videos
Your Say

Documented cases of canine coronavirus have been linked to pneumonia
|GETTY
Most humans have no immunity to either virus, and a Chinese strain of influenza D has already gained the ability to pass between people.
Influenza D virus was first identified back in 2011 and has since been found in pigs, cows, poultry, deer, giraffes, and even kangaroos.
The virus is thought to contribute to bovine respiratory disease, which costs the American cattle industry roughly $1billion annually.
Concerningly, studies of cattle workers in Colorado and Florida revealed that up to 97 per cent of those working closely with herds carry antibodies for the virus, suggesting widespread exposure.
So far, these infections haven't caused any symptoms in people. But scientists say influenza D shows all the signs of a virus ready to evolve rapidly.
LATEST DEVELOPMENTS
Canine coronavirus, which causes gut problems in dogs, is a different beast from the virus behind Covid-19.
Although human infections remain rare, documented cases have been linked to pneumonia hospitalisations in Southeast Asia.
In 2017, a University of Florida team isolated the virus from a medical worker who had travelled from Florida to Haiti and developed mild fever and fatigue.
Then in 2021, scientists discovered a nearly identical strain in a child hospitalised in Malaysia.
The same strain has since turned up in people with respiratory illness in Thailand, Vietnam, and Arkansas, showing it's already spreading across continents.
These discoveries echo a familiar lesson from recent pandemics: without proper preparation, a virus that develops efficient human-to-human spread can quickly become a major epidemic.
Scientists are calling for improved virus monitoring
|GETTY
The researchers are calling for improved virus monitoring, more reliable diagnostic tests, treatments, and potentially vaccines.
"Our review of the literature indicates these two viruses pose respiratory disease threats to humans, yet little has been done to respond to or prevent infection from these viruses," said co-author John Lednicky, a research professor at the University of Florida.
The authors wrote that despite limited data, "these novel, newly detected viruses indicate that they are a major threat to public health."
Our Standards: The GB News Editorial Charter










